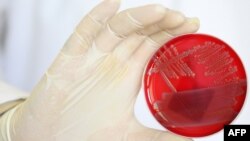
Напередодні деякі медіа повідомили про спалах скарлатини у Києві. Фото ілюстративне

У Києві за десять місяців зареєстровано 375 випадків скарлатини, з них 372 випадки – серед дітей до 17 років, повідомляє пресслужба Міністерство охорони здоров’я.
«Поодинокі випадки були зареєстровані у різних групах та класах та є характерними серед захворювань, які щороку реєструють на території країни. Протиепідемічні заходи у школах посилено», – йдеться у повідомленні.
У МОЗ наголошують, що наразі динаміка захворювання не вказує на спалах. Наприклад, у 2019 році у Києві було зафіксовано 1996 випадків скарлатини, у 2020 році – 656 випадків. У відомстві додають, що у країнах з помірно холодним і вологим кліматом, як в Україні, випадки захворювання здебільшого реєструють восени і взимку.
Напередодні деякі медіа опублікували матеріали про спалах скарлатини у Києві.
Скарлатина – гостре інфекційне захворювання, яке проявляється ураженням мигдаликів ротоглотки і характерним висипом. У більшості випадків скарлатина розпочинається раптово. Розвивається ангіна, язик спочатку «біліє» і до четвертого дня захворювання стає червоним, на шкірі хворого виникає характерний висип – дрібні яскраво-рожеві або червоні цятки, які часто сверблять.
На скарлатину найчастіше хворіють діти віком 1-9 років. Шлях інфікування – повітряно-краплинний. Зокрема, під час кашлю, чхання і навіть розмови хворого.
Захворювання може мати легкий, середній чи важкий перебіг. За легкої форми симптоми інтоксикації організму слабо виражені, блювота відсутня, ангіна. У разі важкої форми початок хвороби супроводжує висока температура, блювота, інколи діарея. Можливі запаморочення, набряк мозку і навіть розвиток коми.
Профілактика поширення хвороби полягає у ранньому виявленні та ізоляції хворого. Пацієнтам, хворим на скарлатину, призначають курс антибіотиків. Якщо антибіотик не призначався, ізоляція має тривати протягом 21 дня.

Форум